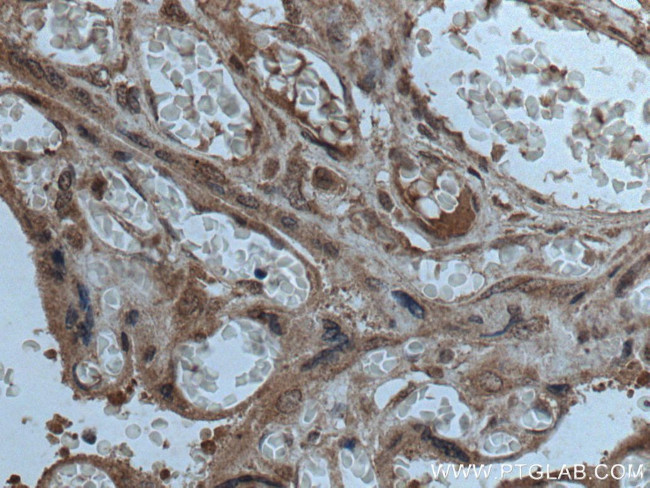
CPZ Antibody in Immunohistochemistry (Paraffin) (IHC (P))

Search
Proteintech
CPZ Polyclonal Antibody
{{$productOrderCtrl.translations['antibody.pdp.commerceCard.promotion.promotions']}}
{{$productOrderCtrl.translations['antibody.pdp.commerceCard.promotion.viewpromo']}}
{{$productOrderCtrl.translations['antibody.pdp.commerceCard.promotion.promocode']}}: {{promo.promoCode}} {{promo.promoTitle}} {{promo.promoDescription}}. {{$productOrderCtrl.translations['antibody.pdp.commerceCard.promotion.learnmore']}}
产品信息
15944-1-AP
种属反应
宿主/亚型
分类
类型
抗原
偶联物
形式
浓度
规格
纯化类型
保存液
内含物
保存条件
运输条件
产品详细信息
Immunogen sequence: GAGYNGWTS GRQNAQNLDL NRNFPDLTSE YYRLAETRGA RSDHIPIPQH YWWGKVAPET KAIMKWMQTI PFVLSASLHG GDLVVSYPFD FSKHPQEEKM FSPTPDEKMF KLLSRAYADV HPMMMDRSEN RCGGNFLKRG SIINGADWYS FTGGMSDFNY LHTNCFEITV ELGCVKFPPE EALYTLWQHN KESLLNFVET VHRGIKGVVT DKFGKPVKNA RISVKGIRHD ITTAPDGDYW RLLPPGIHIV IAQAPGYAKV IKKVIIPARM KRAGRVDFIL QPLGMGPKNF IHGLRRTGPH DPLGGASSLG EATEPDPLRA RRQPSADGSK PWWWSYFTSL STHRPRWLLK Y (303-652 aa encoded by BC006393)
靶标信息
CPZ is a member of the metallocarboxypeptidase family. This enzyme displays carboxypeptidase activity towards substrates with basic C-terminal residues. It is most active at neutral pH and is inhibited by active site-directed inhibitors of metallocarboxypeptidases.
仅用于科研。不用于诊断过程。未经明确授权不得转售。
生物信息学
蛋白别名: Carboxypeptidase Z; CPZ; epididymis secretory sperm binding protein; metallocarboxypeptidase with N-terminal frizzled domain; metallocarboxypeptidase Z; unnamed protein product; VEZT/CPZ fusion
基因别名: AV136066; CPZ
UniProt ID: (Human) Q66K79, (Rat) O54858, (Mouse) Q8R4V4
Entrez Gene ID: (Human) 8532, (Rat) 83575, (Mouse) 242939